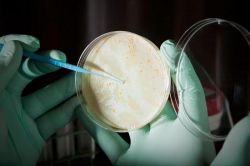
Анализ на чувствительность к антибиотикам: как сдавать, расшифровка результатов

Что показывает анализ крови на ПЦР? Как подготовиться к анализу
Диагностика инфекционных заболеваний разного типа – как вирусных, так и бактериальных – направлена на выявление возбудителей на ранней стадии, что даёт возможность назначить своевременное и особенно эффективное лечение. Самым современным методом обнаружения инфекций является ПЦР, который расшифровывается как полимеразная цепная реакция. В чём суть данного метода и с какой целью он проводится?
Гладких Ася